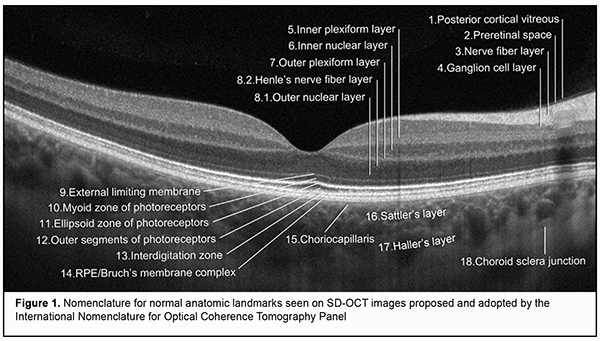

J.ophthalmol.(Ukraine).2020;4:62-68.
|
http://doi.org/10.31288/oftalmolzh202046268 Received: 08 May 2020; Published on-line: 27 August 2020 Current view on retinal OCT imaging nomenclature and terminology N.S. Lutsenko, O.A. Rudycheva, O.A. Isakova, T.S. Kyrylova Zaporizhzhia Medical Academy of Post-Graduate Education; Zaporizhzhia (Ukraine) E-mail: rudychevaolga5@gmail.com TO CITE THIS ARTICLE: Lutsenko NS, Rudycheva OA, Isakova OA, Kyrylova TS. Current view on retinal OCT imaging nomenclature and terminology. J.ophthalmol.(Ukraine).2020;4:62-68. http://doi.org/10.31288/oftalmolzh202046268 Optical coherence tomography (OCT) is an essential non-invasive and non-contact diagnostic modality in ophthalmology which allows detailed visualization of posterior segment structures. There have been numerous publications on OCT imaging terminology and OCT-based identification and discrimination of retinal and choroidal structures. Variability in the views of authors and researchers on retinal layer structure as seen on OCT resulted in changes in the nomenclature over the years. The purpose of this review was to generalize and systematize the existing terms constituting an OCT lexicon and relevant to identification of the posterior segment structure and description of structural changes. Knowledge of the nomenclature for OCT and relevant terminology will be essential for experience sharing among ophthalmologists and enable better understanding of pathological retinal and choroidal changes, resulting in improved quality of OCT diagnostic studies. Keywords: optical coherence tomography, retina, nomenclature, terminology
Fundus examination is an essential tool for diagnosing ocular as well as systemic diseases. For decades routine ophthalmoscopy had been the only modality available for detecting retinal pathologies, and the ideas about morphological changes in the retina were based only on histological evidence and clinical experience. These diagnostic limitations resulted in the development of technologies allowing detailed imaging of retinal structures and recording and analysis of these images [1]. In 1991, Fujimoto and colleagues from Massachusetts Institute of Technology reported on the development of the first optical coherence tomography (OCT) instrument. OCT is based on the analyses of light interference properties generated by near-infrared light which is split into and recombined from a reference and sample arm [2]. The use of these physical phenomena enabled the researchers to obtain in vivo images of the tissue under study and to determine its morphological structure. Specifically, more detailed imaging of the vitreous, retinal layers, retinal pigment epithelium (RPE), choroid, and optic nerve structures (the optic disc and lamina cribrosa) has become available. Therefore, posterior segment OCT has become an essential non-invasive and non-contact diagnostic modality enabling high-resolution imaging of biological tissues in vivo and providing valuable aid in clinical practice and research [3, 4, 5, 6, 7, 8, 9]. In addition, advanced OCT modalities, such as spectral domain OCT (SD-OCT), high-definition SD-OCT and swept-source OCT were developed in the early twenty-first century. This substantially improved the quality of OCT images (OCT can image with axial resolutions of 1 to 10 ?m), which brought the method closer to histopathology, and enabled examining architectural morphology and some cell functions [9, 10, 11]. Therefore, OCT has become an important diagnostic tool that can perform a type of “optic biopsy” [12, 13, 14]. It is noteworthy, however, that microscopy and OCT differ in image contrast mechanisms used when performing biopsy. Thus, OCT employs light waves and identifies differences in refractive index and scattering coefficient for various tissues, which depends on tissue density differences. In microscopy, an image is formed due to differences in the amount of light absorbed or optical refraction from microscopic sections. Elements of microscopic slide structure partially absorb and reflect light falling on them, which results in image formation [15]. Therefore, there is a difference in imaging result between OCT imaging and histopathology imaging, and much confusion has arisen about interpretation of the data obtained with regard to clinically significant ocular pathologies [16, 17, 18, 19]. At the same time, advances in technology have enabled a more detailed assessment of retinal structure and allocation of additional retinal imaging zones (the outer limiting membrane, RPE, and the interdigitation zone [20]). First, the views on imaging of certain posterior segment structures on OCT have changed as the technology updated. Second, the OCT images obtained did not always correspond to histological evidence [17, 21, 22]. Thus, the retina can be divided histologically into 10 layers [23]. However, OCT shows significantly more retinal structures than histology due to morphological features of retinal tissue structures that differ in reflectivity and become visible on OCT images [24]. That is why definitions for various retinal layers changed frequently in the literature and were often inconsistent with retinal anatomy and histology. Newly obtained knowledge had to be clarified and arranged systematically, and the terms and nomenclature had to be revised. In 2014, an international panel with expertise in retinal imaging (International Nomenclature for Optical Coherence Tomography [IN • OCT] Panel) was assembled to develop a consensus for the classification of retinal and choroidal layers and bands visible on SD-OCT images of a normal eye. A nomenclature system for normal anatomic landmarks (Fig. 1) seen on SD-OCT outputs has been proposed and adopted by the IN • OCT Panel. The panel recommended this standardized nomenclature for use in future publications [20]. Specifically, the panel introduced the term "zone" for OCT features that seem to localize to a particular anatomic region that lacks definitely proven evidence for a specific reflective structure. In addition, the panel avoided the use of the term “line,” which is not relevant to anatomic correlates because a “line” is a 1-dimensional structure. The experts showed agreement with regard to identification of some hyper- and hyporeflective layers of the posterior eye, and substantial disagreement with regard to identification of other hyper- and hyporeflective layers of the posterior eye. Thus, the experts were unanimous on what the OCT layer represented in anatomic terms, as well as consistency of nomenclature, with regard to the ganglion cell layer, inner and outer plexiform layers, inner nuclear layer, and choroidal-scleral juncture. The list of the layers where there were both disagreements on what the OCT layer represented along with inconsistencies of nomenclature is as follows: the nerve ?ber layer; outer nuclear layer; myoid zone and ellipsoid zones of the photoreceptors; cone interdigitation with RPE; and choriocapillaris. In particular, disagreements related to descriptions of the boundaries between retinal subcompartments or where the separation between the tomographic layers was poor owing to poor resolution and merging of bands. As a result, the IN • OCT Panel identified 18 anatomic zones, each representing a different reflective region on OCT. Table 1 lists the 18 zones of the posterior segment in numerical order, along with acronyms of their names and OCT descriptions.
Therefore, with regard to the 18 zones, a process of open discussion and negotiation was undertaken until a unanimous consensus name was adopted for each feature. The goal of the panel was to codify current understanding and provide a framework to integrate future developments. A limitation of the review [20] is that the panel assigned names based on contemporaneous concepts; if history is any guide, they are likely to need revision in the future. The proposed harmonizing of terminology serves as a basis for future OCT research studies. Several reviews have been published on the consensus nomenclature for posterior segment structures [22, 25, 26]. Thus, Shpak [27] reviewed differences between the older conventional nomenclature and the recommended nomenclature proposed by the [IN • OCT] consortium, and generalized information in the latter nomenclature (Table 2).
De?nitions for various layers changed frequently in the literature and were often inconsistent with retinal anatomy and histology, which caused reviewing of the older conventional nomenclature and introducing of new terms in OCT lexicon. The consensus nomenclature for retinal structures introduced almost no change relevant to the morphological structure of the inner retina. The internal limiting membrane (ILM) is a very thin structure formed by the footplates of M?eller cells and which closely adheres to the nerve fiber layer. Because it can practically not be differentiated on OCT imaging, it has not been recognized as a distinct zone in the recommended nomenclature proposed by the [IN • OCT] consortium. It is noteworthy that OCT studies of the outer retina have significantly changed current thinking on the structure of the retina, which resulted in the introduction of several definite concepts, i.e., terms [18]. Prior to the review by Staurenghi et al [20], the terms myoid and ellipsoid had been used in the conventional biological literature, and it was that review that for the first time used the terms myoid zone and ellipsoid zone to describe photoreceptors on OCT images. It seems reasonable, because these structures differ in reflectivity on, and are well outlined and identified by OCT. The myoid zone of the photoreceptors (myoid portion of the inner segments) contains the cell structures (the endoplasmic reticulum and Golgi apparatus) having low optical density; therefore, the zone is hyporeflective, similar to the nuclear layers. The ellipsoid zone is formed basically by the ellipsoid portion of the photoreceptors which are packed with mitochondria and have the potential for high reflectivity; the zone is hyperreflective, similar to the RPE/Bruch’s membrane complex. In our point of view, the consensus nomenclature also introduced a substantial change relevant to the outer portion of the outer segments of photoreceptors. This zone has been attributed to cone outer segment tips (COST) line or rod outer segment tips (ROST) line or Verhoeff’s membrane [28, 29]. Verhoeff’s membrane, however, is not a real membrane but has been described as the tight junctional complexes between RPE cells that are visible as a band on electron microscopy. Because the band is in the region where the interdigitation should occur, the IN • OCT panel, therefore, agreed that this band should be termed the “interdigitation zone”. The zone may represent the interdigitation of the apical processes of the RPE with the cone outer segments. In addition, this zone may be difficult to detect on OCT, because it appears as a bright (hyperreflective) band anterior or superior to the RPE, and this band is difficult to differentiate from the hyperreflective RPE layer even in healthy patients [30, 31]. Moreover, because the concept of interdigitation (interdigitatsiia) is widely used in the Ukrainian- and Russian-language cytology literature, and it is reasonable to use a conventional medical term also in the Ukrainian- and Russian-language OCT literature, we believe that the term “interdigitation zone” (i.e., cone interdigitation with retinal pigment epithelium) should be translated from English to Ukrainian or Russian using a transliteration-based approach. Interdigitation is defined as a type of interlocking between cells with finger-like cell membrane invagination. Interdigitation contributes to improved strength of connections between cells and increased cell-to-cell contact surface [32]. It is noteworthy that, previously, the RPE/Bruch’s membrane complex had other names and was interpreted in other way [25]. The single band previously attributed to the RPE can now occasionally be seen as 2 distinctive hyperreflective bands separated by a hypore?ective zone on SD-OCT or swept-source OCT images. This single band was previously called the RPE line or the RPE/Bruch's membrane/choriocapillaris complex. The IN • OCT group agreed that the two above-mentioned hyperreflective bands correspond with the RPE and Bruch’s membrane and that they are often not separable under normal conditions. The RPE/Bruch's complex thickness is thicker at the foveola than at other retinal locations. In RPE detachment, the Bruch's membrane appears at detachment sites as a thin band of moderate reflectivity. Advanced OCT modalities allow not only good visualization of low and high reflectivity structures of the retina and choroid. Thus, the choroidal layers (zones), the choriocapillaris, Sattler’s and Haller’s layers, and choroidal-scleral juncture were included in the consensus nomenclature with account of their different optical densities and the absence of distinct margins. The choriocapillaris is a thin layer of moderate reflectivity in inner choroid which underlies the RPE/Bruch's membrane complex. The Sattler’s layer is a thick layer of round or oval-shaped hyperre?ective pro?les with hypore?ective cores in mid-choroid; it is comprised of medium choroidal vessels in mid-choroid. The Haller’s layer is a thick layer of oval-shaped hyperre?ective pro?les with hypore?ective cores in outer choroid; it is comprised of large choroidal vessels that are located adjacent both to the lamina fusca and suprachoroidal space. The choroidal-scleral juncture appears on OCT as a homogenous region of variable reflectivity. Clear detection and marking of this junction is important for correct measurement of choroidal thickness; normally, choroidal thickness at the macula is 300 to 320 ?m. In recent years, there has been increased clinician interest in choroidal thickness measurements [33, 34]. Because various chorioretinal disorders affect choroidal thickness, measuring the choroidal thickness may help differentiate between disorders and assess treatment efficacy [35, 36, 37, 38]. Therefore, in sum, the inner retina can be divided histologically into 6 layers, and divided on OCT into 5 layers, because the internal limiting membrane has the same reflectivity as the nerve ?ber layer and thus cannot be differentiated from it. In addition, the outer retina can be divided histologically into 4 layers and divided on OCT into 7 layers. This is because photoreceptor portions vary in reflectivity, and thus the photoreceptor layer is the region of variable reflectivity. Moreover, although previously, the choroid has been considered as a single unit, now advanced OCT images allow conducting more detailed studies, dividing it into 4 layers and identifying vessels of various sizes within it. In general, the consensus nomenclature for OCT findings in normal eyes is harmonized with the histological structure of the eye, allows adequate understanding of posterior segment structure in normal eyes, and serves as a basis for further advanced OCT diagnostic studies. We, however, believe that it is also important to understand ocular pathological changes shown by SD-OCT which may not differ in characteristics among ocular structures or vice versa. Adequate interpretation and simultaneous and consistent step-by-step description of morphological changes are essential for further advances in OCT-based diagnostics in posterior segment pathology. It is this that can facilitate communication among researchers and help develop a single scientific point of view on the basis of novel knowledge. Implementing this idea required also either codifying the already existing terminology relevant to description of morphological changes on OCT scans or assigning particular definitions to images. In the national literature, there has been published a book on this topic. Included in this book is a glossary, a detailed list of specific terms with their interpretations, comments and schematics (Fig. 2) [8].
In conclusion, we hope that the information we provided helps our colleagues reshape their views on the changes in the nomenclature and terminology, and properly use the consensus nomenclature for OCT findings in normal eyes in their professional activities. It stands to reason that common understanding and consistent communication using understandable professional language will enable further professional development and experience. References 1.Gabriele ML, Wollstein G, Ishikawa H, Kagemann L, Xu J, Folio LS, Schuman JS. Optical coherence tomography: History, current status, and laboratory work. Invest Ophthalmol Vis Sci. 2011;52:2425–36. 2.Fujimoto J, Swanson E. The development, commercialization, and impact of optical coherence tomography. Invest Ophthalmol Vis Sci. 2016;57:OCT1–13. 3.Naithani P, Sihota R, Sony P, Dada T, Gupta V, Kondal D, Pandey RM. Evaluation of optical coherence tomography and heidelberg retinal tomography parameters in detecting early and moderate glaucoma. Invest Ophthalmol Vis Sci. 2007 Jul 1;48(7):3138–45. 4.Pircher M, Zawadzki RJ. Review of adaptive optics OCT (AO-OCT): principles and applications for retinal imaging [Invited]. Biomed Opt Express. 2017 May 1;8(5):2536. 5.Jonnal RS, Kocaoglu OP, Zawadzki RJ, Liu Z, Miller DT, Werner JS. A review of adaptive optics optical coherence tomography: Technical advances, scientific applications, and the future. Invest Ophthalmol Vis Sci. 2016 Jul 1;57(9):OCT51-68 6.Aznabaev BM, Mukhamadeev TR, Dibaev TI. [Optical coherence tomography + angiography of the eye]. Moscow: Avgust Borg; 2015. Russian. 7.Daker DS, Ve`khid NK, Goldman DR. [Retinal Optical Coherence Tomography]. 2nd ed. Moscow: MEDpress-inform; 2019. Russian. 8.Lutsenko NS, Rudycheva OA, Isakova OA, Kyrylova TS, Unguryan NV. Macula. Modern diagnostics. (Optical coherence tomography and Optical coherence tomography angiography). Zaporizhzhya: Agentstvo Orbita-YuG; 2019. Ukrainian. 9.de Boer JF, Leitgeb R, Wojtkowski M. Twenty-five years of optical coherence tomography: the paradigm shift in sensitivity and speed provided by Fourier domain OCT. Biomed Opt Express. 2017 Jul 1;8(7):3248–80. 10.Aumann S, Donner S, Fischer J, M?ller F. Optical Coherence Tomography (OCT): Principle and Technical Realization. In: High Resolution Imaging in Microscopy and Ophthalmology. Springer International Publishing; 2019. p. 59–85. 11.Popescu DP, Choo-Smith LP in., Flueraru C, Mao Y, Chang S, Disano J, Sherif S, Sowa MG. Optical coherence tomography: Fundamental principles, instrumental designs and biomedical applications. Biophysical Reviews. 2011 Sep;3(3):155. 12.Cheng J, Sohn EH, Jiao C, Adler KL, Kaalberg EE, Russell SR, Mullins RF, Stone EM, Tucker BU, Han IC. Correlation of optical coherence tomography and retinal histology in normal and Pro23His retinal degeneration pig. Transl Vis Sci Technol. 2018 Nov 1;7(6):18. 13.Fatehee N, Yu PK, Morgan WH, Cringle SJ, Yu DY. Correlating morphometric parameters of the porcine optic nerve head in spectral domain optical coherence tomography with histological sections. Br J Ophthalmol. 2011 Apr [cited 2020 Apr 7];95(4):585–9. Available from: http://www.ncbi.nlm.nih.gov/pubmed/21156705 14.Berger A, Cavallero S, Dominguez E, Barbe P, Simonutti M. Spectral-Domain Optical Coherence Tomography of the Rodent Eye: Highlighting Layers of the Outer Retina Using Signal Averaging and Comparison with Histology. PLoS One [Internet]. 2014 [cited 2020 Apr 7];9(5):96494. Available from: www.plosone.org 15.Fujimoto JG, Pitris C, Boppart SA, Brezinski ME. Optical Coherence Tomography: An Emerging Technology for Biomedical Imaging and Optical Biopsy. Neoplasia [Internet]. 2000 Jan [cited 2020 Apr 25];2(1–2):9–25. Available from: https://linkinghub.elsevier.com/retrieve/pii/S1476558600800172 16.Xie W, Zhao M, Tsai SH, Burkes WL, Potts LB, Xu W, Payne HR, Hein TW, Kuo L, Rosa LHJ. Correlation of spectral domain optical coherence tomography with histology and electron microscopy in the porcine retina. Exp Eye Res. 2018 Dec 1;177:181–90. 17.Chen TC, Cense B, Miller JW, Rubin PAD, Deschler DG, Gragoudas ES, de Boer JF. Histologic Correlation of In Vivo Optical Coherence Tomography Images of the Human Retina. Am J Ophthalmol. 2006 Jun 1;141(6):1165–8. 18.Eagle Jr. RC. Optical Coherence Tomography: Clinicopathologic Correlations - The 2016 Gordon K. Klintworth Lecture. Ocul Oncol Pathol [Internet]. 2018 Jun 1 [cited 2020 Apr 7];4(4):203–12. Available from: https://www.karger.com/Article/FullText/484321 19.Pinilla I, Ruiz-Moreno JM, Cuenca N. Correlation of optical coherence tomography with retinal histology. Arch Soc Esp Oftalmol. 2012;87(9):275–7. 20.Staurenghi G, Sadda S, Chakravarthy U, Spaide RF. Proposed lexicon for anatomic landmarks in normal posterior segment spectral-domain optical coherence tomography: The IN OCT consensus. Ophthalmology. 2014 Aug;121(8):1572-8 21.Dysli C, Enzmann V, Sznitman R, Zinkernagel MS. Quantitative analysis of mouse retinal layers using automated segmentation of spectral domain optical coherence tomography images. Transl Vis Sci Technol. 2015 Jul 1;4(4):9–9. 22.Turgut B. Past and Present Terminology for the Retinal and Choroidal Structures in Optical Coherence Tomography. Eur Ophthalmic Rev. 2017;11(01):59. 23.Tsang SH, Sharma T. Retinal histology and anatomical landmarks. In: Advances in Experimental Medicine and Biology. Springer New York LLC; 2018. p. 3–5. 24.Lumbroso B., Huang D., Gia Y., Rispoli M., Romano A. VN. Clinical OCT Angiography Atlas [Internet]. 2nd ed. New Delhi: Jaypee Brothers medical Publishers; 2015 [cited 2020 Apr 17]. 182 p. Available from: https://www.bookdepository.com/Clinical-OCT-Angiography-Atlas-Bruno-Lumb... 25.Turgut B, Demir T. The new landmarks, findings and signs in optical coherence tomography. New Front Ophthalmol. 2016;2(3). 26.Huynh E, Chandrasekera E, Bukowska D, McLenachan S, Mackey DA, Chen FK. Past, Present, and Future Concepts of the Choroidal Scleral Interface Morphology on Optical Coherence Tomography. Asia Pac J Ophthalmol (Phila). Jan-Feb 2017;6(1):94-103. 27.Shpak АА. New nomenclature of optical coherence tomography. Oftalmokhirurgiya. 2015;3:80–2. Russian. 28.Verhoeff FH. A Hitherto Undescribed Membrane of the Eye and Its Significance. Bost Med Surg J. 1903;15:309–19. 29.Byeon SH, Kang SY. Interpretation of Outer Retina Appearance in High-resolution Optical Coherence Tomography. Am J Ophthalmol. 2009;147(1):185–6. 30.Spaide RF, Curcio CA. Anatomical correlates to the bands seen in the outer retina by optical coherence tomography: Literature Review and Model. Retina. 2011;31(8):1609–19. 31.Lumbroso B, Rispoli M, Carpineto P, Catalano S, Serru A. Practical handbook of OCT: (retina, choroid, glaucoma). 209 p. 2nd ed. New Delhi: Jaypee Brothers Medical Publishers; 2015. 32.Lutsyk OD, Chaikovskyi YuB, Bilyi RO, Boichuk TM, Vasko LV, Volkov KS. [Histology. Cytology. Embryology: a textbook for students]. Vinnytsia: Nova knyha; 2020. Ukrainian. 33.Dansingani KK, Balaratnasingam C, Naysan J, Freund KB. En face imaging of pachychoroid spectrum disorders with swept-source optical coherence tomography. Retina. 2016;36(3):499–516. 34.Cheung CMG, Lee WK, Koizumi H, Dansingani K, Lai TYY, Freund KB. Pachychoroid disease. Eye. 2019;33:14–33. 35.Hoseini-Yazdi H, Vincent SJ, Collins MJ, Read SA, Alonso-Caneiro D. Wide-field choroidal thickness in myopes and emmetropes. Sci Rep. 2019 Dec 1;9(1):3474. 36.Asanad S, Ross-Cisneros FN, Barron E, Nassisi M, Sultan W, Karanjia R, Sadun AA. The retinal choroid as an oculovascular biomarker for Alzheimer’s dementia: A histopathological study in severe disease. Alzheimer’s Dement (Amst). 2019 Nov 9;11:775-783. . 37.Chirco KR, Sohn EH, Stone EM, Tucker BA, Mullins RF. Structural and molecular changes in the aging choroid: Implications for age-related macular degeneration. Eye (Basingstoke). Nature Publishing Group; 2017;31:10–25. 38.Zhao J, Wang YX, Zhang Q, Wei W Bin, Xu L, Jonas JB. Macular Choroidal Small-Vessel Layer, Sattler’s Layer and Haller’s Layer Thicknesses: The Beijing Eye Study. Sci Rep. 2018 Dec 1;8(1):4411.
The authors certify that they have no conflicts of interest in the subject matter or materials discussed in this manuscript.
|